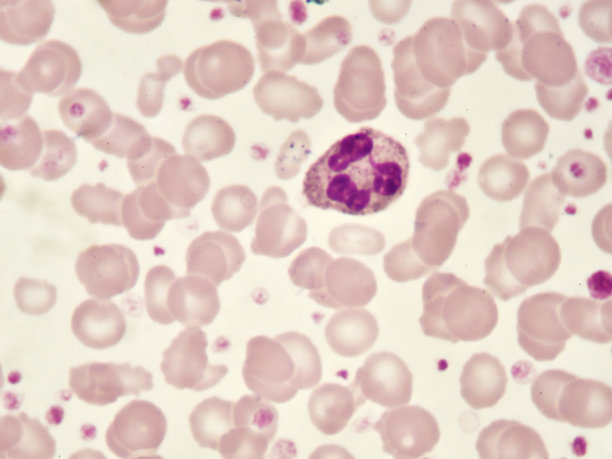
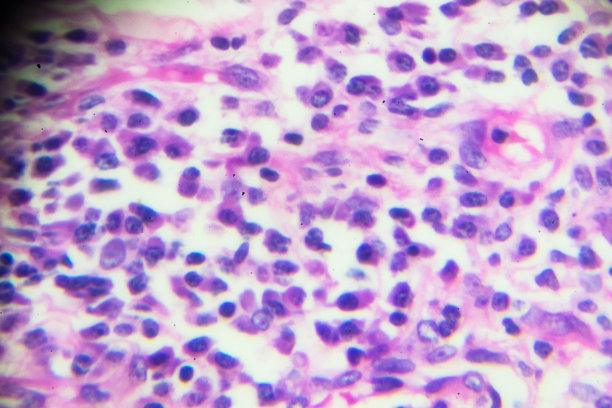

嗜中性粒细胞

请先登录后再下载
58明星,嗜中性粒细胞,嗜碱细胞,白细胞,骨髓膜,单核细胞,血液学,血小板,细胞核,传染病,显微镜载玻片,癌症,白血病,慢性疾病,微生物学,细胞,显微镜,血液,有毒生物体,药,实验室,生病,泰国,奇异的,红色,健康保健,生长,摄影,水平画幅,4K分辨率,图像